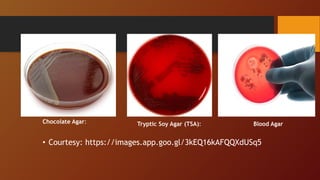
• Tryptic Soy Agar (TSA):
Chocolate Agar: Tryptic Soy Agar (TSA): Blood Agar
• Courtesy: https://images.app.goo.gl/3kEQ16kAFQQXdUSq5

The document covers various types of microbial media used in microbiology, categorizing them into natural, synthetic, complex, selective, differential, indicator, enriched, and enrichment media. Each type of media serves specific functions for culturing microorganisms, with detailed examples and applications, such as nutrient agar for general culturing and MacConkey agar for isolating gram-negative bacteria. Additionally, it discusses the importance of nutrient composition and the role of specific indicators in distinguishing between microbial species.